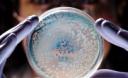

–Ф–Ј–µ–±–∞–Ї –Т–ї–∞–і–Є–Љ–Є—А
–†–Ю–Ч–Ф–£–Ь–Ш –Я–†–Ю –Э–Р–Ф–Т–Р–Ц–Ы–Ш–Т–Х –∞–±–Њ –І–Ю–Ь–£ –Э–Р–®–Ж –Ю–Ы–Ж–У–Р–†–•–Ш –°–Ґ–Р–Ы–Ш –Ь–Ю–У–Ш–Ы–ђ–©–Ш–Ъ–Р–Ь–Ш –Э–Ш–Э–Ж–®–Э–ђ–Ю–З –£–Ъ–†–Р–З–Э–Ш
–Ф–Ј–µ–±–∞–Ї –Т–ї–∞–і–Є–Љ–Є—А
–†–Ю–Ч–Ф–£–Ь–Ш –Я–†–Ю –Э–Р–Ф–Т–Р–Ц–Ы–Ш–Т–Х –∞–±–Њ –І–Ю–Ь–£ –Э–Р–®–Ж –Ю–Ы–Ж–У–Р–†–•–Ш –°–Ґ–Р–Ы–Ш –Ь–Ю–У–Ш–Ы–ђ–©–Ш–Ъ–Р–Ь–Ш –Э–Ш–Э–Ж–®–Э–ђ–Ю–З –£–Ъ–†–Р–З–Э–Ш

–У–Њ–ї–Њ–≤–љ–Є–Љ —Ц–љ—Б—В—А—Г–Љ–µ–љ—В–Њ–Љ –љ–Є–љ—Ц—И–љ—Ц—Е –Њ–ї—Ц–≥–∞—А—Е—Ц–≤ —Ф –±–µ–Ј–њ—А–∞–≤–љ–Є–є –ї—О–Љ–њ–µ–љ, —П–Ї–Є–є –ґ–Є–≤–µ –љ–∞ –њ–Њ–і–∞—З–Ї–∞—Е –≤—Ц–і –і–µ—А–ґ–∞–≤–Є, –љ–∞ –≥—А–∞–љ—Ц —Д—Ц–Ј–Є—З–љ–Њ–≥–Њ –≤–Є–ґ–Є–≤–∞–љ–љ—П. –Ю—Б—М —З–Њ–Љ—Г –Ј–љ–∞—З–љ–∞ —З–∞—Б—В–Є–љ–∞ –њ–µ–љ—Б—Ц–Њ–љ–µ—А—Ц–≤ —Ф –љ–∞–є–Ї—А–∞—Й–Є–Љ —Ч—Е –µ–ї–µ–Ї—В–Њ—А–∞—В–Њ–Љ, —П–Ї–Є–є —Ц –і–Њ–њ–Њ–Љ–∞–≥–∞—Ф —З–∞—Б—В–Њ –њ—А–Є–≤–Њ–і–Є—В–Є –і–Њ –≤–ї–∞–і–Є —Ч—Е —Б—В–∞–≤–ї–µ–љ–Є–Ї—Ц–≤. –Ф–ї—П –Љ–∞–ї–Њ–≥–Њ —Ц —Б–µ—А–µ–і–љ—М–Њ–≥–Њ –±—Ц–Ј–љ–µ—Б—Г —Б—М–Њ–≥–Њ–і–љ—Ц –Ј–∞–Ї—А–Є—В—Ц –µ–Ї–Њ–љ–Њ–Љ—Ц—З–љ—Ц –ї—Ц—Д—В–Є —Г —Ж—Ц–ї–Є—Е –≥–∞–ї—Г–Ј—П—Е –µ–Ї–Њ–љ–Њ–Љ—Ц–Ї–Є, –±–Њ –Ј –Ї–Њ–ґ–љ–Є–Љ —А–Њ–Ї–Њ–Љ —Б—Д–µ—А–Є –Ј–∞—Ж—Ц–Ї–∞–≤–ї–µ–љ–Њ—Б—В—Ц –Њ–ї—Ц–≥–∞—А—Е—Ц—Ч –Ј–±—Ц–ї—М—И—Г—О—В—М—Б—П, –њ–µ—А–µ–Ї—А–Є–≤–∞—О—З–Є –Ї–Є—Б–µ–љ—М —Г—Б—Ц–Љ —Ц–љ—И–Є–Љ.